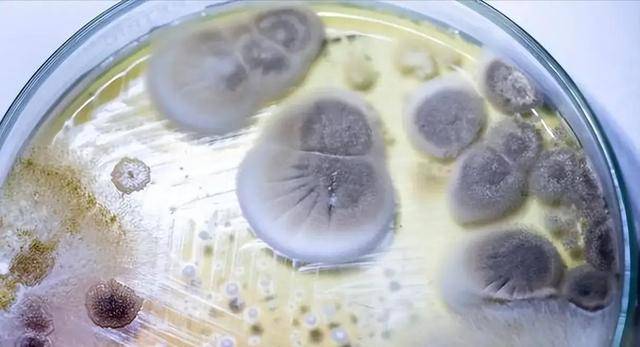

2026年的第一场食品安全地震,就这样从一盘再普通不过的炒粿条开始了。

截至目前,数十人先后被送进医院,其中两条生命永远停在了那个夜晚。医生的诊断报告上写着三个字:米酵菌酸。
这三个字对大多数人来说陌生得像是在读天书,但它在毒理学界的凶名,足以让任何一个懂行的人倒吸一口凉气。

你有没有想过,为什么煮熟的食物也会要人命?大多数人从小就听过这个说法:只要彻底加热,细菌病毒统统完蛋。这话放在99%的情况下都没毛病,但米酵菌酸偏偏就是那个1%。
它的耐热性变态到了什么程度?实验室数据明明白白地写着:120℃高压蒸煮,依然无法将它摧毁。你在家里的高压锅、电蒸箱、猛火爆炒,在它面前统统等于给它的蛋白质结构挠痒痒。

这不是危言耸听,这是分子层面的铁证。
更可怕的是它的杀人速度。医学研究表明,米酵菌酸进入人体后,直接瞄准细胞的能量工厂——线粒体。它阻断呼吸链的方式,用一个形象的比喻就是:瞬间拉闸断电。

想象一下,一个城市突然失去所有电力,公共交通瘫痪、电梯停摆、医院ICU的呼吸机集体黑屏。人体的器官也是这个道理,只不过断电的不是电网,而是每一个活细胞的能量供应系统。
肝衰竭、肾衰竭、意识障碍——这些词听起来像是慢性的老年病描述,但在米酵菌酸面前,它们的进展速度堪比高铁。

抢救窗口几乎为零,因为从你感到不适到器官崩溃,中间可能只有几个小时。而这短短几小时里,医生能做的只有一件事:血液透析。对症支持,维持生命体征,除此之外别无他法。
你可能会问:那就没有解药吗?
答案是残酷的:没有。这种毒素没有特效解毒剂,没有针对性的抗毒血清,没有任何能让你松一口气的“解药”。现代医学在它面前,第一次感受到了什么叫束手无策。

好了,说完它的凶残,该聊聊它是怎么长出来的了。
米酵菌酸的产生离不开一种叫椰毒假单胞菌的东西——现在学名是唐菖蒲伯克霍尔德氏菌,听着像是个洋气的外国名字。

它对生活环境挑剔得很,专挑淀粉类食物下手:久泡的玉米面、发酵的湿面、还有东南亚餐桌上最常见的湿米粉和粿条。
更要命的是,它对温度的要求跟人类夏天的空调房差不多——20到37摄氏度,既不太冷也不太热,湿度还得跟上。

换句话说,你家厨房的室温,恰恰是它的五星级套房。
宝林茶室的后厨到底出了什么问题?据调查,涉事的湿河粉和粿条被常温堆放在潮热环境中,整整一个白天,椰毒假单胞菌就在里面开派对、搞繁殖、疯狂生产米酵菌酸。

等到傍晚,这些被毒素浸透的食材被端上炒锅,送进毫无戒备的食客嘴里。
你以为餐厅老板会不知道?后厨管理的那点猫腻,业内人士心知肚明。几十块钱的冷藏成本,和食客的健康甚至生命,你猜他会选哪个?答案往往让人寒心。
但餐厅只是冰山一角。真正让人细思极恐的是,这种细菌的生长条件太普通了,普通到它可能就藏在你家厨房的某个角落里。

现在有一种很奇怪的风潮:什么东西加上“古法”、“天然”、“自制”的标签,身价立马翻倍。
朋友圈里晒的手工酸奶、家里阳台上的发酵米糕、妈妈牌自制酸菜——这些东西在很多人眼里代表的是“安全”、“放心”、“无添加”。

可真相恰恰相反。椰毒假单胞菌最爱的就是发酵环境。那些打着“天然发酵”旗号的食品,恰恰是为它量身定做的豪华住宅。你以为你在享受传统工艺的魅力,实际上你可能正在亲手培育一屋子的致命菌群。
2020年黑龙江那起“酸汤子”事件,不知道还有多少人记得。一家人吃了自制的发酵玉米面制品,结果9口人全部死亡。

消息传到南方,很多人第一反应是:东北的事,跟我有什么关系?河南永城那起凉皮事件,两姐妹一死一重伤,南方人又开始庆幸自己不爱吃凉皮。
结果呢?2026年的这记回旋镖,正中台湾——河粉、粿条、肠粉,这些南方人餐桌上再常见不过的食物,居然成了米酵菌酸的载体。讽刺吗?简直是教科书级别的“我以为离我很远”。

说到这里,必须谈谈一个让人心酸的现实:米酵菌酸最爱的猎物,往往是那些最舍不得扔东西的人。
老年人节俭,这是刻在骨子里的习惯。馒头稍微发黄,削掉皮继续吃;木耳泡了两三天,觉得水还是清的,照样下锅;剩饭剩菜放了一夜,热一热就能吃。

这些行为在年轻人眼里是“不讲究”,但在他们看来,这叫“不浪费”。
问题是,椰毒假单胞菌可不会因为你节省就对你手下留情。相反,它最喜欢的就是那种“还能吃”、“问题不大”的模糊地带。你以为的“将就一下”,在它眼里就是“请君入瓮”。

更让人无奈的是,这些老人家往往是最固执的。你跟他们讲米酵菌酸,他们听不懂;你跟他们说120℃灭不了活,他们觉得你在胡说;你劝他们扔掉那碗泡了三天的木耳,他们心疼得直皱眉。
这种认知上的代际鸿沟,可能比任何毒素都更难攻克。

年轻一代呢?别以为自己就能置身事外。那些追求“健康生活”的都市白领,自制酸奶、自酿米酒、DIY各种稀奇古怪的“天然酵素”——你们以为自己在追赶潮流,实际上可能正在给椰毒假单胞菌创造新的温床。
发酵这个过程,本身就是一场和细菌的博弈。你以为你控制了温度、时间、菌种,但看不见的变量太多太多。

一道无解的毒素,一种无处不在的细菌,一连串看似平常却暗藏杀机的日常习惯——好像怎么防都防不住,怎么躲都躲不了。但事情真的绝望到这种地步吗?
也不尽然。米酵菌酸虽然凶险,但它不是随机出现的凶手,它有明确的作案条件:特定的食材、特定的温度、特定的时间。只要掐断其中任何一个环节,它就无法得逞。
湿米粉、粿条、河粉——这些高危食品,买回来第一时间放冰箱冷藏,千万别图省事就丢在厨房角落过夜。如果发现食材有任何异味、变色、黏腻的迹象,别犹豫,直接扔掉。
做菜的时候,现做现吃,别让成品在室温下停留超过两小时。至于那些自制的发酵食品,如果没有十足的把握和严格的品控,还是去正规渠道购买有质量保证的产品吧。

说到底,食品安全从来不是一个人的事。它需要餐厅老板的良知,需要监管部门的力度,需要媒体的监督,更需要每一个普通人的警觉。
笔者以为,这场悲剧给我们最深的教训,不是米酵菌酸有多可怕,而是一个被说了无数遍却始终被忽视的道理:食物是有脾气的,你得学会尊重它。
该冷的别让它热着,该扔的别舍不得扔,别让那些你以为的“节俭”和“天然”,最终成为压垮生命的最后一根稻草。

| 欢迎光临 辽宁养老服务网 (http://bbs.lnylfw.com/) | Powered by Discuz! X2 |